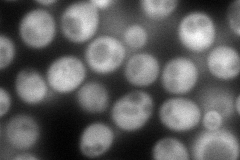

View description
Protein of unknown function, highly conserved across species and homologous to human gene C7orf20; interacts with Mdy2p; genetic interactions predict a role in insertion of tail-anchored proteins into the ER membrane
Localization:
Intensity:
Fold change:
Significance:
-
C’ GFP library in SD

below threshold14.13 -
N' NOP1pr-GFP in SD
cytosol198.801 -
N' TEF2pr-mCherry in SD

cytosol229.672 -
N' NATIVEpr-GFP in SD

missing0 -
N' TEF2pr-VC and Cyto-VN in SD

#N/A0 -
C’ GFP library in SD+DTT

cytosolN/AN/ANo -
C’ GFP library in SD+H2O2

cytosolN/AN/ANo -
C’ GFP library in Starvation Media

technical problem0N/AYes -
C’ GFP library on the background of Pup2-DaMP

below threshold -
C’ GFP library on the background of CCT mutant

below thresholdN/AN/ANo
